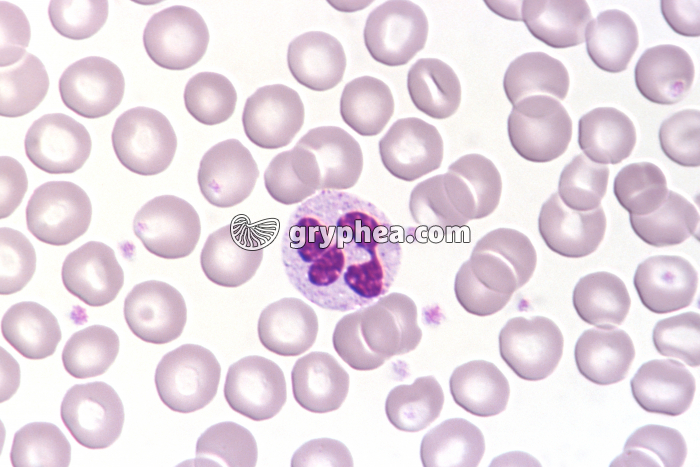
Granulocyte Neutrophile x400 - gryphea.com

1 crédit = 6.00€ TTC
(Hors pack)
si vous êtes enseignant, le site gryphea.org a été conçu spécialement pour vous !
Le sang renferme et véhicule de nombreuses cellules appartenant au système immunitaire. Les principales d‘entre elles sont aisément identifiables sur un frottis sanguin observé à fort grossissement au microscope optique. La coloration caractéristique permettant cette identification est la coloration de May-Grunewald Giemsa, la plus utilisée en hématologie.
- les lymphocytes apparaissent sous la forme de petites cellules à noyau ovoïde, au cytoplasme rare (petits lymphocytes) ou un peu plus abondant (grands lymphocytes)
- les granulocytes ont une taille nettement plus grande, et se reconnaissent à leur noyau lobé ou irrégulier. Dans leur cytoplasme, des inclusions permettent de discriminer les G. neutrophiles, au cytoplasme clair (les plus nombreux), des G. éosinophiles, au cytoplasme bourré de granules de teinte rose à grise, et des G. basophiles, au cytoplasme rempli de granulations denses bleues à violettes.
- les monocytes, au noyau globalement oblong ou en forme de grain de haricot
- les cellules dendritiques, au cytoplasme[...]
La suite du commentaire est réservée aux inscrits, créez un compte gratuitement.